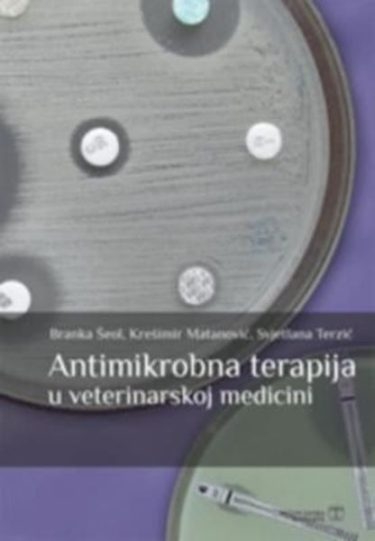
Antimikrobna terapija u veterinarskoj medicini

otvori filter
otvori filter
otvori filter
otvori filter
otvori filter
otvori filter